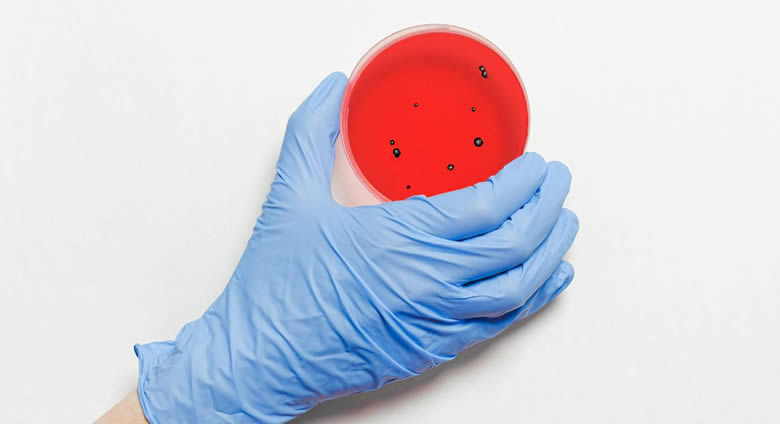

|
 |
|
Dzisiaj jest: sobota, 13 czerwca 2026 r.
(164 d.r.) |
|
|
|
Jutro (jeżeli będzie!): niedziela, 14 czerwca 2026 r. |
|
Ś.D. Krwiodawstwa, Dzień Dziennikarza Obywatelskiego |
|
|
| |||||||||||||||
serwis IKP / sprawy mieszkańców ZP / nasze zdrowie / Pęka nasz klosz bezpieczeństwa epidemiologicznego





|

 |
warto pomyśleć? |  |
|
Jeśli będzie trzeba, zrobię to co będzie trzeba.
(podniesione z ulicy)
|
||
 |
 |
 |
 |
||||||||||||||||||
|
|||||||||||||||||||
 NA SKRÓTY NA SKRÓTY |
|
|

 |
||

Pęka nasz klosz bezpieczeństwa epidemiologicznego
|
| zdjęcie dodane przez Anna Shvets: https://www.pexels.com/pl-pl/zdjecie/reka-trzyma-plytke-petriego-3786245/ |
27-03-2025
Z powodu stylu życia i braku szczepień przypominających wśród dorosłych pęka klosz bezpieczeństwa epidemiologicznego - powiedział naczelny epidemiolog Uniwersyteckiego Szpitala Klinicznego we Wrocławiu prof. Jarosław Drobnik. Zalecił, by ponawiać szczepienia.
Podczas konferencji prasowej w środę we Wrocławiu naczelny epidemiolog Uniwersyteckiego Szpitala Klinicznego prof. Jarosław Drobnik ocenił, że dotychczas mieliśmy poczucie bezpieczeństwa epidemiologicznego, bo tzw. wyszczepialność w przypadkach szczepień obowiązkowych wśród dzieci wciąż wynosi ok 90 proc., choć powinna sięgać nawet 95 proc.
"Jednak na naszych oczach ten klosz bezpieczeństwa nad nami pęka i to z dwóch powodów. Przede wszystkim nie stosujemy tzw. dawek przypominających wśród dorosłych po upływie kolejnych 10 lat, a to jest warunek, by nadal być bezpiecznym, bo z wiekiem tracimy odporność. Druga kwestia to nasz styl życia" - powiedział lekarz.
Wyjaśnił, że chodzi o podróże w różne miejsca świata, w których sytuacja epidemiczna jest niepewna, "w których endemicznie występują choroby zakaźne". "Jeździmy wszędzie, nie zdając sobie sprawy z tego, że trafiamy w miejsca, w których endemicznie występują choroby zakaźne. Tak samo do nas przyjeżdżają z tych samych miejsc ludzie o bardzo niepewnym statusie epidemiologicznym" - powiedział prof. Drobnik.
 |
| (fot. źródła) |
Ocenił, że wiele osób podróżujących w egzotyczne miejsca często przyjmuje szczepienia na "wyimaginowane, rzadkie choroby" typu cholera, malaria, tyfus, podczas gdy nie ma odporności na takie niebezpieczeństwo, które mogą wywołać tężec, krztusiec, polio czy błonica.
"Musimy wrócić do szczepień i do dawek przypominających co 10 lat. A w niektórych chorobach, jak np. sezonowe, nawet co roku" - powiedział epidemiolog. Podkreślił, że ponawianie dawek nie jest kosztowne. Szczepionka, np. na błonicę, tężec, krztusiec i polio kosztuje około 200 zł. Można ją u lekarza rodzinnego otrzymać niemal od ręki.
W zeszłym tygodniu we Wrocławiu stwierdzono u sześcioletniego dziecka błonicę. Nie było ono szczepione. Wróciło z wakacji w Afryce, z Zanzibaru. Stan chorego dziecka lekarze określają jako ciężki, ale stabilny. Objawy kliniczne tej choroby ma też dorosły pacjent, który miał kontakt z dzieckiem w szpitalu. Jest leczony w tym kierunku, choć zakażenia nie potwierdzają jeszcze badania mikrobiologiczne.
Błonica, określana też jako dyfteryt, krup lub dławiec, jest ostrą i ciężką chorobą zakaźną wywoływaną przez bakterie zwane maczugowcami błonicy.
Kierownik Kliniki Pediatrii i Chorób Infekcyjnych USK we Wrocławiu prof. Leszek Szenborn powiedział, że z powodu braku obowiązkowych szczepień wśród wszystkich dzieci nie tylko pojawiają się przypadki błonicy w Europie, ale spory problem stanowią też liczne zachorowania np. na odrę.
"Odra powróciła. W zeszłym roku w Europie mieliśmy 130 tys. zachorowań i 19 przypadków śmierci dzieci z powodu odry. Państwo przyszliście zainteresowani jednym przypadkiem błonicy zawleczonej u dziecka, które było niezaszczepione, ale problem jest większy" - powiedział prof. Szenborn.
Ocenił, że chore na błonicę dziecko mogło w Polsce być bezpieczne, bo jego rówieśnicy byli niemal w komplecie zaszczepieni. Sytuacja zmieniła się, gdy takie niezaszczepione dziecko wyjechało w miejsce, w którym zagrożenia są większe.
"Coraz bardziej obniżamy procenty zaszczepionych, co znacząco wpływa na stan odporności populacyjnej. To nie jest straszenie, ale błonica jest najstraszniejszą z tych wszystkich chorób. ( ) Przypadki błonicy stwierdza się w Czechach, w Niemczech i to nie w pojedynczych przypadkach. W Czechach w ubiegłym roku było 12 przypadków, a w Niemczech w 2023 r. 120 przypadków" - powiedział lekarz.
Wyjaśnił, że błonica jest chorobą podstępną wywołaną nie tylko bakteriami, ale również toksyną. Dlatego zwalczanie bakterii w leczeniu ma działanie podrzędne. "Ta toksyna jest od samego początku zakażenia wytwarzana, działa i wiąże się z naszymi tkankami, truje i zabija komórki. Skuteczność leczenia polega na podaniu immunoglobuliny, surowicy koni. Podaje się przeciwciała pobrane od koni immunizowanych tymi bakteriami" - powiedział lekarz.
Dodał, że również z braku szczepień chorujemy na inne zakaźne choroby i od początku roku do połowy marca w Polsce 64 osoby zachorowały na sepsę meningokokową.
"Nie przejmujemy się tym, podczas gdy śmiertelność w tej chorobie to minimum 10 proc. Więc pewnie sześć osób zmarło. Tak jak nie przejmowaliśmy się tym, że z powodu covidu tygodniowo w Polsce umierało 8 tys. osób. Wypieramy dziś tamten czas, uważamy, że to był jakiś zły sen" - mówił prof. Szenborn.
Podkreślił, że warto się szczepić, warto zrobić wszystko, by uniknąć zakażeń, ponieważ każda choroba zakaźna niesie za sobą ryzyko kalectwa i śmierci. Przypomniał, że ustawowy dokument, jakim jest wydawany na każdy rok "Program szczepień ochronnych" zawiera zalecenie, że każdy dorosły po ukończeniu 19 lat powinien co 10 lat przyjąć kolejną dawkę przeciwko błonicy, ksztuścowi i tężcowi.
"Obawiamy się, bo okazało się, że większość lekarzy, którzy się tym dzieckiem z błonicą zajmowali, nie była również zabezpieczona. Dopiero po tym zdarzeniu musiała się doszczepić przeciwko błonicy. Ci, którzy byli najbliżej, musieli wziąć chemioprofilaktykę, żeby znieść nosicielstwo" - powiedział prof. Szenborn.
Podkreślił, że potencjał dla chorób zakaźnych jak błonica tworzą właśnie ludzie, którzy nie mają odporności. "To dziecko stało się źródłem zakażenia drugiego dorosłego pacjenta, który tylko przebywał na tej sali. Wcale nie miał z tym dzieckiem bardzo bliskiego kontaktu" - powiedział lekarz.
Prof. Szenborn przypomniał, że tylko ponowne szczepienia osób dorosłych na błonicę, tężec i krztusiec zagwarantują odporność populacyjną. "Do połowy marca w Polsce mieliśmy 37 tys. zachorowań na krztusiec. To jest kolejna epidemia. W Czechach, które są trzy razy mniejszym społeczeństwem niż nasze, była podobna liczba zachorowań. A przecież polio było kiedyś główną przyczyną kalectwa" - powiedział lekarz.
red.
źródła: https://naukawpolsce.pap.pl/
| idź do góry | powrót |
 |
|
|
|







